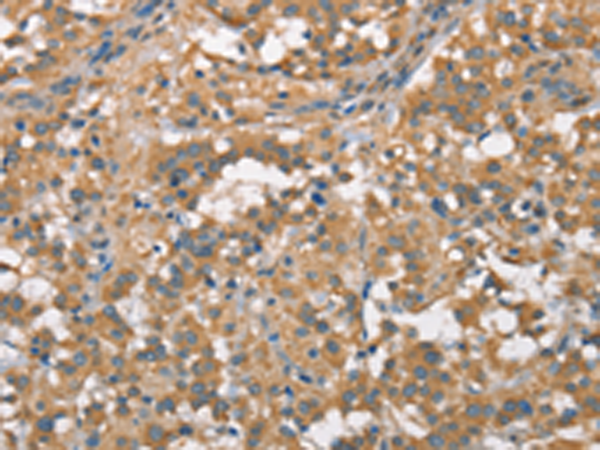

-
分类: 科研抗体货号: P01221别名: CN1; CPGL2; HsT2308应用: WB,IHC反应种属: Human, Mouse, Rat
-
分类: 科研抗体货号: P01216别名: OC120; CKIP-1; RP11-458I7.3应用: WB,IHC反应种属: Human, Mouse, Rat
-
分类: 科研抗体货号: P01280别名: REDD2; Rtp801L应用: IHC反应种属: Human, Mouse, Rat
-
分类: 科研抗体货号: P01214别名: CIDE3; FPLD5; FSP27; CIDE-3应用: WB,IHC反应种属: Human, Mouse, Rat
-
分类: 科研抗体货号: P01328别名: STA; EDMD; LEMD5应用: WB反应种属: Human
-
分类: 科研抗体货号: P01278别名: WS3; p27; WS-3应用: WB,IHC反应种属: Human, Mouse
-
分类: 科研抗体货号: P01305别名: EPF5; E2EPF; E2-EPF应用: WB,IHC反应种属: Human, Mouse, Rat
-
分类: 科研抗体货号: P01326别名: CED12; CED-12; ELMO-1应用: WB,IHC反应种属: Human, Mouse
-
分类: 科研抗体货号: P01277别名:应用: WB,IHC反应种属: Human, Mouse
-
分类: 科研抗体货号: P01302别名:应用: WB反应种属: Human

鄂公网安备42018502007531号
鄂公网安备42018502007531号

